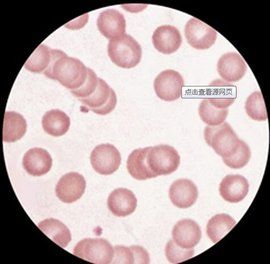
緡錢狀

紅細胞表現
緡錢狀臨床結論:提示血液粘度教高,紅細胞已基本失去活力,紅細胞有效的表面積大量減少,導致氧氣輸送發生極大障礙。如果該狀況不能及時糾正,患者就會出現疲乏、衰弱、瞌睡。
如果再繼續發展將形成緡錢狀重度,紅細胞已完全失去活力它不僅限制了氧氣的自由交換,而且減少了通過毛細血管的血流量。此時,單個紅細胞不僅一個個相互疊加,而且在血中形成紅細胞團塊,若不採取及時有效的治療措施,則會形成大的血凝塊,造成血管內堵塞。
血小板聚焦
緡錢狀臨床參考結論:血小板形成的聚集團塊可以阻塞血管,增加血粘度,使血流緩慢,導致血栓形成。血小板呈葡萄狀聚積,血液處於高凝狀態,血液病或代謝障礙。常見於冠心病、心肌梗塞、腦血栓、高血壓、高血脂、糖尿病等。